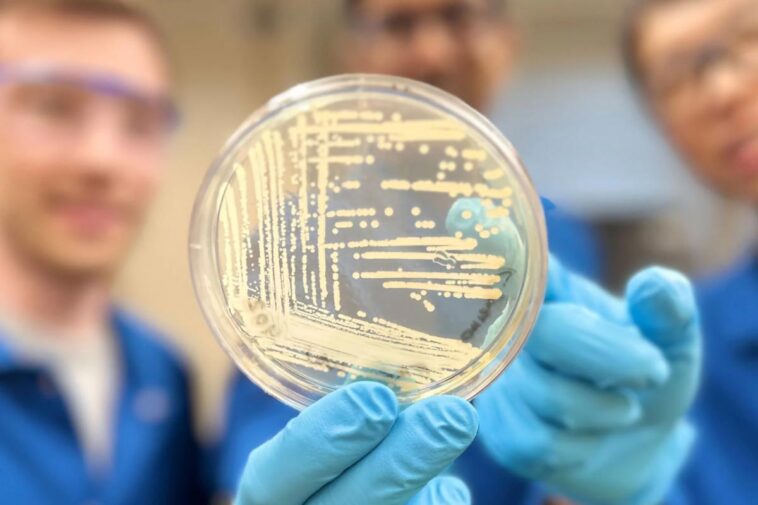
SciTechDaily

Une plaque de gélose contenant des colonies de Klebsiella pneumoniae bactérie, l’une des souches résistantes aux médicaments que le composé synthétique crésomycine a démontré pouvoir combattre. Crédit : Groupe de recherche Myers
La crésomycine, un antibiotique révolutionnaire développé par des scientifiques de Harvard, cible les bactéries résistantes aux médicaments avec une meilleure liaison aux ribosomes, offrant ainsi un espoir contre la résistance mondiale aux antimicrobiens.
Un nouvel antibiotique créé par des chercheurs de Harvard surmonte les mécanismes de résistance aux antimicrobiens qui ont rendu inefficaces de nombreux médicaments modernes et sont à l’origine d’une crise mondiale de santé publique.
Une équipe dirigée par Andrew Myers, professeur Amory Houghton de chimie et de biologie chimique, rapporte dans Science que leur composé synthétique, la crésomycine, tue de nombreuses souches de bactéries résistantes aux médicaments, notamment Staphylococcus aureus et Pseudomonas aeruginosa.
« Bien que nous ne sachions pas encore si la crésomycine et les médicaments similaires sont sûrs et efficaces chez l’homme, nos résultats montrent une activité inhibitrice considérablement améliorée contre une longue liste de souches bactériennes pathogènes qui tuent plus d’un million de personnes chaque année, par rapport aux médicaments cliniquement approuvés. antibiotiques », a déclaré Myers.
Avancées dans les stratégies antibactériennes
La nouvelle molécule démontre une capacité améliorée à se lier aux ribosomes bactériens, qui sont des machines biomoléculaires qui contrôlent la synthèse des protéines. La perturbation de la fonction ribosomale est une caractéristique de nombreux antibiotiques existants, mais certaines bactéries ont développé des mécanismes de protection qui empêchent les anciens médicaments de fonctionner.
La crésomycine est l’un des nombreux composés prometteurs développés par l’équipe de Myers, dans le but d’aider à gagner la guerre contre les superbactéries. Ils continueront à faire progresser ces composés grâce à des études de profilage précliniques, soutenues par une subvention de 1,2 million de dollars du Combating Antibiotic-Resistant Bacteria Biopharmaceutical Accelerator (CARB-X). CARB-X, partenariat mondial à but non lucratif basé à l’Université de Boston, se consacre à soutenir la recherche et le développement d’antibactériens à un stade précoce.
Vue d’ensemble et gros plan de la crésomycine liée au ribosome bactérien de Thermus thermophilus. Crédit : Yury Polikanov/Université de l’Illinois à Chicago
La nouvelle molécule de l’équipe de Harvard s’inspire des structures chimiques des lincosamides, une classe d’antibiotiques qui comprend la clindamycine couramment prescrite. Comme de nombreux antibiotiques, la clindamycine est fabriquée par semisynthèse, dans laquelle des produits complexes isolés de la nature sont modifiés directement pour des applications médicamenteuses. Le nouveau composé de Harvard, cependant, est entièrement synthétique et présente des modifications chimiques inaccessibles par les moyens existants.
« Le ribosome bactérien est la cible préférée de la nature pour les agents antibactériens, et ces agents sont la source d’inspiration de notre programme », a déclaré le co-auteur Ben Tresco, étudiant à la Kenneth C. Griffin Graduate School of Arts and Sciences. « En tirant parti de la puissance de la synthèse organique, nous sommes limités presque uniquement par notre imagination lors de la conception de nouveaux antibiotiques. »
Surmonter la résistance bactérienne
Les bactéries peuvent développer une résistance aux antibiotiques ciblant les ribosomes en exprimant des gènes qui produisent des enzymes appelées ribosomes. ARN méthyltransférases. Ces enzymes éliminent les composants du médicament conçus pour s’accrocher et le perturber, bloquant ainsi l’activité du médicament.
Pour contourner ce problème, Myers et son équipe ont conçu leur composé dans une forme rigidifiée qui ressemble beaucoup à sa cible de liaison, lui donnant ainsi une meilleure adhérence sur le ribosome. Les chercheurs appellent leur médicament « pré-organisé » pour la liaison ribosomale, car il n’a pas besoin de dépenser autant d’énergie pour se conformer à sa cible que les médicaments existants doivent le faire.
Les chercheurs sont arrivés à la crésomycine en utilisant ce qu’ils appellent la synthèse basée sur les composants, une méthode mise au point par le laboratoire Myers qui consiste à construire de grands composants moléculaires d’égale complexité et à les rassembler à des stades ultérieurs – comme la pré-construction de sections d’un ensemble LEGO compliqué avant l’assemblage. eux. Ce système modulaire entièrement synthétique leur permet de fabriquer et de tester non pas une, mais des centaines de molécules cibles, accélérant ainsi considérablement le processus de découverte de médicaments.
Les enjeux sont clairs. « Les antibiotiques constituent la base sur laquelle repose la médecine moderne », a déclaré Kelvin Wu, co-auteur et étudiant diplômé. « Sans antibiotiques, de nombreuses procédures médicales de pointe comme les interventions chirurgicales, les traitements contre le cancer et les transplantations d’organes ne peuvent être réalisées. »
Soutien et orientations futures
La recherche sur la synthèse basée sur les composants de Myers a reçu le soutien précoce du Blavatnik Biomedical Accelerator de Harvard, qui fait partie de l’Office of Technology Development, qui a accordé un financement au laboratoire de Myers en 2013 pour permettre l’essai de composés médicamenteux. Le Bureau de développement technologique a protégé les innovations du Myers Research Group et, avec l’accélérateur biomédical Blavatnik, soutiendra l’équipe de recherche pendant toute la durée de l’accord CARB-X. Le financement CARB-X récemment accordé permet aux chercheurs de continuer à profiler et à optimiser les pistes de médicaments.
« Le financement et d’autres soutiens de groupes comme le Blavatnik Biomedical Accelerator et CARB-X sont essentiels à la découverte et au développement de nouveaux antibiotiques », a déclaré Curtis Keith, directeur scientifique de l’accélérateur de Harvard. « Ces innovations du Myers Research Group ont le potentiel de produire de nouveaux médicaments qui répondront un jour à un besoin mondial en matière de santé.
Pour en savoir plus sur cette découverte, voir Des scientifiques développent un nouvel antibiotique révolutionnaire.
Le travail publié a été soutenu par le Instituts nationaux de la santé et la Fondation nationale de la science.